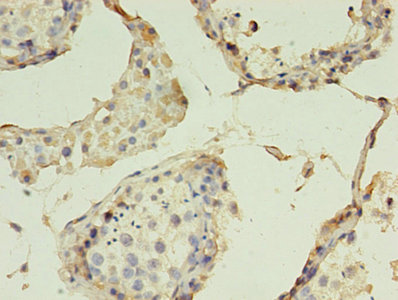
Product Image

Description
CLDN15 Antibody (PACO25785)
CLDN15 Antibody is a premium polyclonal that offers outstanding performance and reliability for demanding research applications. Rigorously validated for ELISA, IHC, IF, this antibody ensures consistent, reproducible results across multiple experimental platforms. Demonstrates excellent reactivity with Human samples, providing researchers with confidence in cross-species compatibility. Conveniently packaged in 50ug format to meet your experimental needs. For optimal performance, store at -20°C or -80°C and maintains stability for 12 months. Backed by rigorous quality control testing to ensure superior performance in your critical research applications.
| Product Name: | CLDN15 Antibody |
| SKU: | PACO25785 |
| Size: | 50μg |
| Isotype: | IgG |
| Host Species: | Rabbit |
| Reactivity: | Human |
| Immunogen: | Recombinant Human Claudin protein (72-128AA) | ||||||
| Immunogen Species: | Homo sapiens (Human) | ||||||
| Uniprot No: | Q96FX9 | ||||||
| Form: | Liquid | ||||||
| Tested Applications: | ELISAIHCIF | ||||||
| Recommended Dilution: |
| ||||||
| Target Names: | CLDN15 | ||||||
| Storage Buffer: | Preservative: 0.03% Proclin 300 Constituents: 50% Glycerol, 0.01M PBS, PH 7.4 | ||||||
| Purification: | >95%, Protein G purified | ||||||
| Clonality: | Polyclonal | ||||||
| Conjugate: | Non-conjugated |